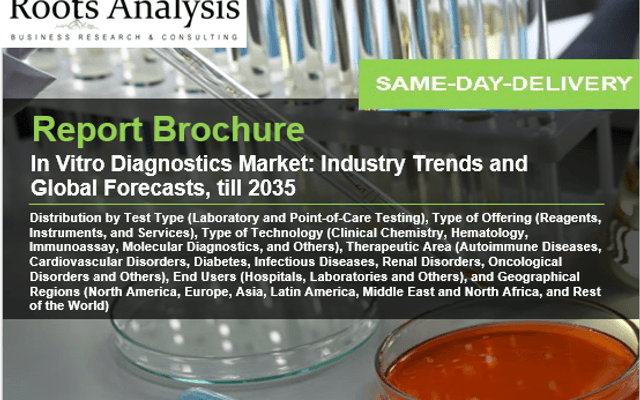
In Vitro Diagnostics Market Size, Share, Growth Factors, Competitive Landscape, with Regional Forecast to 2035

CAR T Cell Therapy Market Key Highlights and Future Opportunities Till 2035
CAR T Cell Therapy Market Forecast to 2035The Global CAR T Cell Therapy Market Report report provides a thorough analysis of the CAR T Cell Therapy market,...
CAR T Cell Therapy Market Forecast to 2035The Global CAR T Cell Therapy Market Report report provides a thorough analysis of the CAR T Cell Therapy market,...
Read more
Read more
The global IVD market size is estimated to grow from $108 billion in 2024 to $190 billion by 2035, growing at a CAGR of 5.2% during the forecast period...
 Read more
Read more
The latest report published by Roots Analysis, titled Point of Care Diagnostics Market offers a detailed study of the industry size, growth scenarios,...
 Read more
Read more
The latest report published by Roots Analysis, titled Healthcare Cybersecurity Market offers a detailed study of the industry size, growth scenarios, and...
 Read more
Read more
The latest drafted document on the global Veterinary Vaccines Market by Roots Analysis, provides a brief discussion on industry size, current growth scenario...
 Read more
Read more
The new market research report titled ‘PARP Inhibitors Market’, published by Roots Analysis offers a comprehensive study of the PARP Inhibitors Market,...